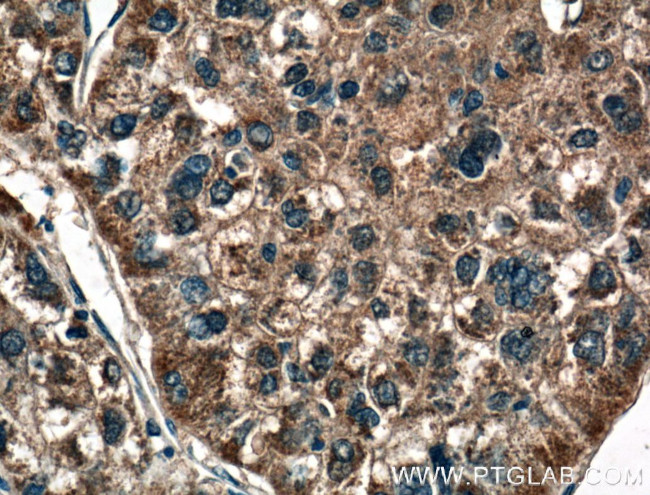
MASP1 Antibody in Immunohistochemistry (Paraffin) (IHC (P))

Search
Proteintech
MASP1 Polyclonal Antibody
{{$productOrderCtrl.translations['antibody.pdp.commerceCard.promotion.promotions']}}
{{$productOrderCtrl.translations['antibody.pdp.commerceCard.promotion.viewpromo']}}
{{$productOrderCtrl.translations['antibody.pdp.commerceCard.promotion.promocode']}}: {{promo.promoCode}} {{promo.promoTitle}} {{promo.promoDescription}}. {{$productOrderCtrl.translations['antibody.pdp.commerceCard.promotion.learnmore']}}
产品信息
21837-1-AP
种属反应
已发表种属
宿主/亚型
分类
类型
抗原
偶联物
形式
浓度
规格
纯化类型
保存液
内含物
保存条件
运输条件
产品详细信息
Immunogen sequence: TFSTRNNLT TYKSEIKYSC QEPYYKMLNN NTGIYTCSAQ GVWMNKVLGR SLPTCLPECG QPSRSLPSLV KRIIGGRNAE PGLFPWQALI VVEDTSRVPN DKWFGSGALL SASWILTAAH VLRSQRRDTT VIPVSKEHVT VYLGLHDVRD KSGAVNSSAA RVVLHPDFNI QNYNHDIALV QLQEPVPLGP HVMPVCLPRL EPEGPAPHML GLVAGWGISN PNVTVDEIIS SGTRTLSDVL QYVKLPVVPH AECKTSYESR SGNYSVTENM FCAGYYEGGK DTCLGDSGGA FVIFDDLSQR WVVQGLVSWG GPEECGSKQV YGVYTKVSNY VDWVWEQMGL PQSVVEPQVE R (379-728 aa encoded by BC106945)
靶标信息
MBL is a key component in immune response in that it can directly trigger neutralization of invading microorganisms by an Ab-independent mechanism. Mutations of human MBL are associated with immunodeficiency resulting from a reduction in the ability of the mutant MBL to initiate complement fixation. In human, three types of MBL-associated serine proteases, MASP-1, MASP-2 and MASP-3, and a truncated form of MASP-2 (small MBL-associated protein; sMAP or MAp19) complex with MBL to activate the lectin pathway of the complement system. MASP-3 is an alternatively spliced product from the MASP-1 gene. The heavy/A chains are identical between MASP-1 and MASP-3 but the light/B chains are entirely different. Activated MASPs subsequently cleave and activate downstream components of the complement pathway.
仅用于科研。不用于诊断过程。未经明确授权不得转售。
生物信息学
蛋白别名: C4/C2 activating component of Ra-reactive factor; complement factor MASP-3; Complement-activating component of Ra-reactive factor; mannan binding lectin serine peptidase 1; mannan-binding; Mannan-binding lectin serine protease 1; mannose-associated serine protease 1; Mannose-binding lectin-associated serine protease 1; Mannose-binding protein-associated serine protease; MASP-1; Ra-reactive factor serine protease p100; RaRF; Serine protease 5; unnamed protein product
基因别名: 3MC1; CRARF; CRARF1; MAP-1; MAP1; MAp44; MASP; MASP-3; MASP1; MASP3; PRSS5; RaRF
UniProt ID: (Human) P48740
Entrez Gene ID: (Human) 5648